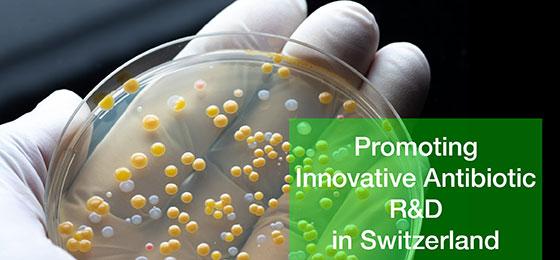

Netzwerkanlass Antibiotikaforschung: Der Markt alleine richtet’s nicht
Die Forschung liefert viele innovative Ansätze für neue Antibiotika, doch nur wenige werden zu marktreifen Medikamenten weiterentwickelt.
Am Netzwerkanlass "Promoting Innovative Antibiotic R&D in Switzerland" vom 24. Juni diskutierten Vertretende von Akademie, Industrie, Politik und Förderinitiativen, wie sich dies ändern lässt.
Das NFP 72 und der Nationale Forschungsschwerpunkt NCCR AntiResist organisierten gemeinsam den online stattfindenden Anlass, an dem knapp 100 Personen teilnahmen. Moderiert wurde der Tag von Malcolm Page, Mitglied der NFP 72-Leitungsgruppe, der sowohl die akademische wie die industrielle Antibiotikaforschung in allen Aspekten hervorragend kennt.
Zum Auftakt legte Ständerätin Maya Graf eine politische Sicht auf die Problematik dar. Darauf zeigte Michael Altorfer, CEO der Swiss Biotech Association, auf, dass die Marktmechanismen bei der Entwicklung neuer Antibiotika seit Jahren nicht mehr greifen. Die Preise für verfügbare Antibiotika sind sehr tief, und neu entwickelte Antibiotika sollten so wenig wie möglich verkauft werden, da sie idealerweise als Reserveantibiotika nur da eingesetzt werden, wo andere versagen.
Vor diesem Hintergrund stellten verschiedene Referentinnen und Referenten Überlegungen an, wie neue Anreizmechanismen den für die Medizin unerlässlichen Nachschub neuer Antibiotika in Zukunft sichern könnten. Nicht zuletzt diskutierten die Teilnehmenden die Rolle staatlicher Akteure, die nebst der Förderung der akademischen Grundlagenforschung stärker auch am anderen Ende des Entwicklungsprozesses ansetzen sollten: Mittels geeigneter finanzieller Vergütungssysteme könnten sie die Entwicklung neuer Medikamente an dem Punkt belohnen, an dem sie tatsächlich auf den Markt kommen.
Während solche Wege bereits länger im Gespräch sind, ohne dass bisher durchschlagende Lösungen umgesetzt wurden, springen derzeit diverse Förderinitiativen in die Lücke. Mit deren Tätigkeiten und Möglichkeiten setzten sich weitere Referate auseinander. Kevin Outterson etwa präsentierte als Direktor das CARB-X Global Partnership, das vor allem dank der Finanzierung durch die USA weltweit Antibiotika-Projekte von kleineren und mittleren Pharmafirmen unterstützt. Seamus O'Brien, Leiter R&D von GARDP (Global Antibiotic Research & Development Partnership), zeigte auf, wie die internationale Non-Profit-Organisation vielversprechende Ansätze für neue Antibiotika auf allen Ebenen fördert. Und Thomas Cueni, Generaldirektor der IFPMA (International Federation of Pharmaceutical Manufactureres & Associations), legte dar, wie die grossen Pharmafirmen mit einem Fonds in Höhe von einer Milliarde Dollar ausgewählte Projekte kleinerer Firmen fördern.
Schliesslich fokussierten mehrere Referate auch auf die Forschung im engeren Sinne und zeigten auf, dass diese auf hohem Niveau zahlreiche Ansätze liefert. Von akademischer Seite sind hierbei das NFP 72 und der NCCR AntiResist besonders zu erwähnen, zudem stellten Vertretende mehrerer Schweizer Unternehmen ihre Forschungstätigkeiten im Antibiotikabereich vor und diskutierten diese, darunter Glenn Dale von BioVersys, Daniel Obrecht von Polyphor, Irene Wüthrich von Myria Biosciences, Laurenz Kellenberger von Basilea und Ken Bradley von Roche.
Es wurde deutlich, dass die Schweiz sowohl in der Akademie wie in der Pharmaindustrie führend auf dem Gebiet der Antibiotikaforschung ist. Gleichzeitig zeigte sich aber auch, dass ein intensiverer Austausch der beiden Seiten die Chancen auf Neuentwicklungen erhöhen würde. Ein Gefäss dazu besteht bereits mit der Antibiotics Platform von biotechnet, die deren Leiter Markus Seeger vorstellte. Es herrschte weitgehende Einigkeit darüber, dass das grosse Potential nur ausgeschöpft werden kann, wenn sich auch die Politik stärker in diesem Bereich engagiert. Der 24. Juni hat in diesem Sinne wichtige Impulse geliefert, die es nun verstärkt auch in die Politik und die Öffentlichkeit zu tragen gilt.
